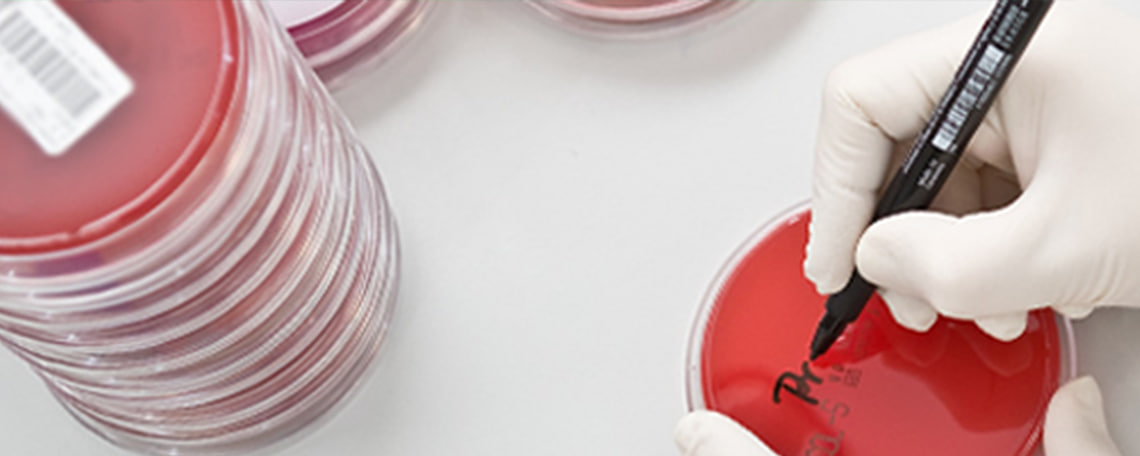
Headerbild Labor Berlin - Charité Vivantes GmbH

KARRIEREMESSE
Gestalte mit uns die Zukunft der Labordiagnostik!
Im Fachbereich Humangenetik Molekulargenetik NGS am Standort Berlin-Wedding (Campus Virchow-Klinikum) besetzen wir ab sofort eine Position als
Wissenschaftlicher Mitarbeiter / Fachhumangenetiker / Bioinformatiker Humangenetik (m/w/d) Schwerpunkt Befundung & Molekulardiagnostik
(Kennziffer: 16431)Warum diese Stelle Dich begeistern wird:
Du möchtest genetische Daten nicht nur analysieren, sondern daraus klinisch relevante Befunde ableiten?
In dieser Position liegt Dein Fokus klar auf der Befundung: Du interpretierst komplexe molekulargenetische Datensätze, bewertest Sequenzvarianten und trägst damit direkt zur Diagnostik hereditärer Erkrankungen bei. Dabei arbeitest Du mit modernen Technologien wie NGS, Sanger und MLPA sowie etablierten Auswertepipelines wie Varvis® in einem akkreditierten Umfeld auf höchstem fachlichen Niveau.
Dich erwartet ein interdisziplinäres Team, das wissenschaftlichen Austausch lebt und Dir Raum für fachliche Weiterentwicklung bietet. Werde Teil der Humangenetik in Europas größtem Krankenhauslabor und gestalte Diagnostik, die wirklich zählt!
Deine Mission bei Labor Berlin:
- Klinische Befundung im Fokus: Auswertung und Befundung molekulargenetischer Daten (NGS, Sanger, MLPA) zur Diagnostik hereditärer Erkrankungen
- Varianten fundiert bewerten: Interpretation und Klassifikation genetischer Varianten nach aktuellen wissenschaftlichen Standards
- Bioinformatische Tools einsetzen: Anwendung und Weiterentwicklung von Auswertepipelines (z. B. Varvis®) sowie Arbeit mit Laborsystemen wie MEDAT und Datenbanklösungen
- Interdisziplinär zusammenarbeiten: Aktive Mitarbeit in einem akkreditierten Team mit engem fachlichen Austausch
Das zeichnet Dich aus:
- Masterabschluss sowie Promotion (zwingend erforderlich) in Biologie, Biomedizin oder einer vergleichbaren Fachrichtung
- Fundierte Kenntnisse in molekulargenetischen Methoden (NGS, Sanger, MLPA)
- Mindestens 1 Jahr Erfahrung in der humangenetischen Diagnostik und Befundung
- Sehr gute Deutschkenntnisse (ab C1)
- Strukturierte, eigenständige Arbeitsweise und Teamfähigkeit
Wir bei Labor Berlin bieten Dir:
- Befristete Festanstellung bis 31.12.2027 (39 Wochenstunden in Vollzeit) im Rahmen einer Elternzeitvertretung
- Reiner Tagdienst: Montag bis Freitag mit Kernarbeitszeit zwischen 09:00 bis 16:00 Uhr
- 30 Tage Urlaub (zusätzlich: 24. + 31.12. frei), flexible und verlässliche Dienst-/Urlaubsplanung
- Bei Umzug nach Berlin: Option zur Anmietung eines möblierten 1-Raum-Apartments, Übernahme der Umzugskosten
- Mitgliedschaft im „Urban Sports Club“, Kinderbetreuung im Krankheitsfall („Kids Mobil“), kostenloser labordiagnostischer Basis-Check
- BVG-Firmenticket, Dienstrad-Leasing („JobRad“), Unterstützung bei der betrieblichen Altersvorsorge, Berufsunfähigkeitsversicherung
- Umfangreiches Fortbildungsprogramm (>100 Veranstaltungen/Jahr u. a. über „Haufe Akademie“), Sommerfest/Weihnachtsfeier, Sportveranstaltungen
Werde ein Teil von Labor Berlin. Wir freuen uns über Deine Bewerbung!
Bewirb Dich ganz einfach mit Deinem Lebenslauf über den Button „Jetzt bewerben“.
Deine Fragen beantwortet gerne Nina Best aus dem Recruiting-Team (Tel.: +49 151 4223 1242).
Labor Berlin trifft seine Personalentscheidungen nach Eignung, Befähigung und fachlicher Leistung. Bei gleicher Eignung bevorzugen wir schwerbehinderte Menschen. Anfallende Kosten für Vorstellungsgespräche werden nicht übernommen.
Aus Gründen der leichteren Lesbarkeit verwenden wir im Textverlauf die männliche Form der Anrede. Selbstverständlich sind bei Labor Berlin Menschen jeder Geschlechtsidentität willkommen.
Labor Berlin - Charité Vivantes GmbH • Abteilung Personal • Sylter Straße 2 • 13353 Berlin
Einblicke in Labor Berlin • Mein Labor • Social-Media-Kanäle















